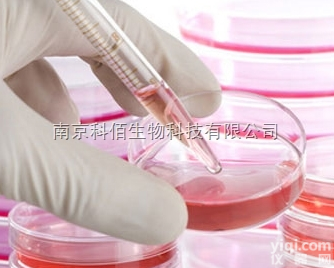
SU-DHL-1 人弥漫性<em>组织</em><em>细胞</em>性<em>淋巴瘤</em>

产品信息
U-937细胞,(组织细胞淋巴瘤细胞)
【规 格】1株/1ML
【储存条件】低温保存
【产品商标】ATCC
【供应限制】仅供科研使用
细胞培养的准备工作一定要做充分,准备至少两套高温高压消毒后的物品,做新的操作时先检点所有的东西是否准备齐全,比如配液时的滤器,分装所用的容器是不是足够等等。所有实验物品,包括自己配的液体和购买的产品,都要标记清楚(比如名称,PH值、时间、还有自己的名字,如果是共用一个冰箱的话这一点很重要)。冻存的物品尽量避免反复冻融,如果无法避免,也要尽早分装,一次用完。U-937细胞,(组织细胞淋巴瘤细胞) 细胞计数在开始培养时很有必要,但计数次数多了经验估计法也是很好的办法,必竟每次计数也不是那么精确,而细胞培养对计数也不是那么要求严格。 一瓶细胞培养用液体尽量不要反复使用,这将增大污染机率。可用的办法即是将其分装成适当规格,一次用1瓶。细胞培养板或瓶若要摞在一起的话,注意在箱内不要超过3层,否则,中间的会受热不均,严重影响细胞质量,可造成细胞生长不均匀,可能造成中间稀少,四周密集。
本公司是一家生物高新技术企业,满足生物化学、分子生物学 、细胞生物学、免疫学 ELISA试剂盒等生物科技实验需求,其主营产品:ELISA试剂盒/人ELISA试剂盒/大鼠ELISA试剂盒/小鼠ELISA试剂盒/金标试剂盒/免疫组化试剂盒/标准品/科研抗体/生化试剂,生物培养基/细胞株/实验室耗材/动物血清等科研产品!
产品展示台:
ELISA试剂盒 科研抗体
小鼠T细胞活化连接蛋白(LAT)ELISA试剂盒 肿瘤坏死因子受体相关因子1抗体
鼠抗子宫内膜抗体(EMAb)ELISA试剂盒 端粒体复制结合因子1抗体
鼠β干扰素(IFN-β/IFNB)ELISA试剂盒 酪氨酸激酶A.B.C抗体
小鼠肌钙蛋白Ⅰ(Tn-Ⅰ)ELISA试剂盒 生精细胞凋亡相关基因3抗体
鼠血清淀粉样蛋白A(SAA)ELISA试剂盒 促甲状腺素受体抗体
ATCC细胞 标准品
人胚肾T细胞 橄榄苦苷
人胚胎皮肤成纤维细胞 党参炔苷
人胚肺二倍体细胞 鼠尾草酸
人胚肾上皮细胞 迷迭香酸
人皮肤成纤维细胞 黄豆黄苷
人胚肺成纤维细胞 染料木素
生化试剂 生物培养基
L-丙氨酸 煌绿乳糖胆盐肉汤 (BGLB)
D-丙氨酸 mEC 肉汤
DL-丙氨酸 沙门氏菌显色培养基
β-丙氨酸 TBX 培养基
BOC-L-丙氨酸 大肠杆菌显色培养基
以上为本公司其他类产品部分展示,如有其他产品需求可来电详询,或登录 查询:信裕生物:http://shxysw.18./
U-937细胞,(组织细胞淋巴瘤细胞) 技术相关问答:
1. 如何选用特殊细胞系培养基?培养某一类型细胞没有固定的培养条件。在MEM中培养的细胞,很可能在DMEM或M199中同样很容易生长。总之,MEM做粘附细胞培养、RPMI-1640做悬浮细胞培养是一个好的开始。2. 何时须更换培养基?视细胞生长密度而定, 或遵照细胞株基本数据上之更换时间,按时更换培养基即可。 3. 可否使用与原先培养条件不同之培养基?不能。每一细胞株均有其特定使用且已适应之细胞培养基, 若骤然使用和原先提供之培养条件不同之培养基, 细胞大都无法立即适应, 造成细胞无法存活。4.可否使用与原先培养条件不同之血清种类?不能。血清是细胞培养上一个极为重要的营养来源,所以血清的种类和品质对于细胞的生长会产生极大的影响。来自不同物种的血清, 在一些物质或分子的量或内容物上都有所不同,血清使用错误常会造成细胞无法存活。
相关产品:
TC-axbz-115 牛胚气管细胞 EBTr (NBL-4)
TC-axbz-119 大鼠心肌细胞 H9c2(2-1)
TC-axbz-120 大鼠肾小球系膜细胞EC (HBZY-1) HBZY-1
TC-axbz-121 绿猴恒河猴肾细胞 LLC-MK2
TC-axbz-125 大鼠肺泡巨噬细胞 NR8383
TC-axbz-126 负鼠肾细胞 OK
TC-axbz-129 猪髋动脉内皮细胞 PIEC
TC-axbz-130 鼠逆转录酶病毒包装细胞 PT67
TC-axbz-131 ZG仓鼠仓鼠肺细胞 R1610
TC-axbz-132 绿猴猴脉络膜-视网膜(内皮)细胞 RF/6A
TC-axbz-133 大鼠雪旺细胞 RSC96
TC-axbz-134 猪睾丸细胞系(ST) ST
TC-axbz-135 蝙蝠肺细胞 Tb 1 Lu
TC-axbz-136 小鼠B细胞杂交瘤细胞 W6/32
TC-axbz-137 鼠纤维肉瘤细胞系 WEHI 164
TC-axbz-138 小鼠B淋巴细胞 WEHI 231
编号 中文 英文名称
TC-axbz-139 大鼠垂体细胞 RPC
TC-axbz-140 小鼠垂体细胞 MPC
TC-axbz-141 兔子垂体细胞
TC-axbz-142 狗垂体细胞
TC-axbz-143 鼠肝癌细胞系 MM45T.Li
TC-axbz-144 小鼠成纤维细胞系 McCoy
TC-axbz-145 大鼠肝癌细胞(乳腺癌细胞接种到肝脏成瘤) Walker-256
TC-axbz-146 大鼠肝癌细胞(wistar 大鼠) CBRH7919
TC-axbz-147 小鼠结肠癌 C26
TC-axbz-148 稳定转染了neor和LIF基因的STO细胞株 SNL
TC-axbz-149 小鼠艾氏腹水瘤细胞 ECA
TC-axbz-150 褐鼠胰岛素瘤上皮细胞 RIN-m
TC-axbz-151 小鼠杂交瘤细胞 ST2/o
TC-axbz-152 小鼠肾癌细胞 RenCa
TC-axbz-153 小鼠胰岛素瘤β细胞(NOD/Lt转基因小鼠,SV40巨T抗原) NIT-1
TC-axbz-154 早代小鼠胚胎成纤维细胞 MEF
TC-axbz-156 兔的肝细胞 VX2
TC-axbz-157 鸡胚原代肝细胞 CEL
TC-axbz-158 129小鼠ES细胞 D3
c BALB/c小鼠ES细胞 B/c-ES
TC-axbz-161 猴的骨髓间充质干细胞 MSCS
TC-axbz-162 SD大鼠骨髓间充质干细胞 SDBMSC
TC-axbz-167 杂交瘤细胞枝原体阳性 B6YH4
编号 中文 英文名称
TC-axbz-169 兔肾细胞系 RK-13
TC-axbz-171 VERO衍生株 SVP
TC-axbz-174 草鱼肾细胞系 GIK
TC-axbz-181 散鳞镜鲤尾鳍细胞
TC-axbz-182 鲤鱼尾鳍细胞
TC-axbz-183 转化的豚鼠胎体细胞 104C1
TC-axbz-184 ZG仓鼠肾细胞(二氢叶酸还原酶缺陷型) CHO/dhFr-
TC-axbz-186 鼠肉瘤细胞 S-180-S2D9
TC-axbz-187 鼠肝癌细胞 H22-H8D8
TC-axbz-188 鼠腹水瘤 EAC-E2G8
TC-axbz-189 小鼠淋巴瘤 EL-4
TC-axbz-192 鲑鱼胚胎细胞 RTG
TC-axbz-193 大黄鱼肾细胞 PCK
TC-axbz-194 鼠腹水单核细胞瘤 J774A.1
TC-axbz-195 小鼠IL-3依赖性32D细胞
TC-axbz-196 大黄鱼EPC细胞 EPC
TC-axbz-197 菜青虫卵巢细胞 Pr-HNV8
TC-axbz-198 大鼠胰岛素细胞 INS-1
TC-axbz-199 小鼠淋巴结血管上皮样细胞 SVEC4-10
TC-axbz-200 小鼠肉瘤 S37
TC-axbz-201 小鼠乳腺 EMT6
TC-axbz-202 C3H小鼠骨肉瘤 LM8
TC-axbz-203 大鼠骨肉瘤 VMR106
TC-axbz-204 猴肾C M145
TC-axbz-205 兔成骨C IF
编号 中文 英文名称
TC-axbz-206 小鼠白血病 L1210
TC-axbz-207 大鼠皮层神经元细胞 RN-c
TC-axbz-208 大鼠主动脉平滑肌细胞 RSMC
TC-axbz-210 鼠杂交骨髓瘤细胞 K6H6/B5
TC-axbz-211 大鼠脑膜细胞 RMC
TC-axbz-212 转基因细胞 3T3/Fas/com
TC-axbz-214 小鼠T淋巴细胞瘤细胞 Cyc-Tag(S49)
TC-axbz-215 小鼠骨髓细胞 FDC-P1
TC-axbz-216 小鼠垂体瘤细胞 GT1-1
TC-axbz-217 小鼠神经母细胞瘤细胞与大鼠胶质瘤细胞之融合细胞 NG108-15
TC-axbz-218 小鼠胚胎成纤维细胞(来自NIH3T3) PA12
TC-axbz-219 小鼠血细胞 WEHI-3
TC-axbz-222 小鼠垂体瘤细胞(分泌促生长激素分泌激素) AtT-20
TC-axbz-227 小鼠原B细胞株 BaF3
TC-axbz-228 小鼠脑瘤细胞 BC3H1
TC-axbz-233 小鼠树突状细胞肉瘤细胞 DCS
TC-axbz-235 新生牛眼晶体上皮细胞 NBLE
TC-axbz-236 新生牛眼Tenon's囊成纤维细胞 NBTF
编号 中文 英文名称
TC-axbz-237 兔角膜后基质层成纤维细胞 RCBBF
TC-axbz-238 兔角膜前基质层成纤维细胞 RCFBF
TC-axbz-240 兔眼Tenon's囊成纤维细胞 RYTF
TC-axbz-241 小鼠乳腺癌细胞 CCC-Ca761-03
TC-axbz-242 果子狸肾上皮细胞 Hed68
TC-axbz-244 小鼠肺腺癌细胞系 LA795
TC-axbz-246 兔晶体上皮细胞永生系 N/N1003A(RLE)
TC-axbz-247 大鼠嗜碱性粒细胞性白血病细胞 RBL-1